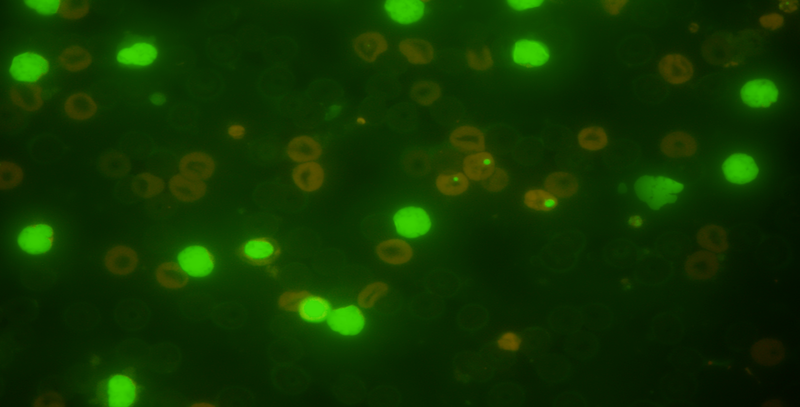

In Vivo Micronucleus Test

The in vivo micronucleus (MN) assay (OECD 474) is a short-term cytogenetic assay for detecting agents that induce chromosomal breakage or damage to the mitotic apparatus. Mice or rats are used to detect micronuclei in immature erythrocytes (polychromatic erythrocytes or reticulocytes) in the bone marrow or peripheral blood. Femoral bone marrow or peripheral blood is evaluated either microscopically or by flow cytometry, respectively, for the presence of polychromatic erythrocytes containing micronuclei.
Micronuclei are essentially small packets containing lagging chromosome fragments or entire chromosomes. An increase in micronucleated polychromatic erythrocytes in treated animals directly indicates chromosome damage.
The typical study design for the in vivo MN test is to use three test article dose levels, concurrent vehicle, and positive controls with two days of dose administration, followed by one collection time point, using six animals/sex/dose level. Plasma is collected for demonstration of bone marrow exposure to the test article. Dose selection is based on a dose range finding test. The in vivo MN assay can be conducted with a single sex if there is no difference in toxicity between the sexes in the dose range finding study.
The in vivo MN assay can also be integrated into repeat dose toxicity testing. Inotiv accepts blood samples stabilized in EDTA or bone marrow smears prepared at other laboratories for micronucleus frequency assessment.
Species: Mouse, Rat
MN Analysis: Microscopy or Flow Cytometry
Mechanism of Action (MoA) Determination for in vivo MN: CREST Antibody Labeling
Labeling bone marrow slides with a CREST (Calcinosis, Raynaud's phenomenon, Esophageal involvement, Sclerodactyly, Telangiectasia) anti-centromere antibody investigates the mode of action of a test article that is positive in an in vivo micronucleus assay. CREST labeling determines whether a micronucleus contains a whole chromosome(s), an indication of an aneugenic mechanism, or chromosome fragment(s), an indication of a clastogenic mechanism. An aneugenic mechanism may allow a threshold for genotoxic damage, which is very important in the overall risk assessment of a compound. The in vivo micronucleus assay is ideal for use as a follow up assay to explore MoA (aneugenic or clastogenic) of an initial genotoxicity result. Slides containing bone marrow depleted of nucleated cells can be prepared for CREST antibody staining using the same animals used in the standard in vivo micronucleus assay design.
In Vivo MN FAQ:
Which species is best to use for in vivo MN?
The most commonly used species are rats and mice. Species selection is often based on test material availability, existing exposure information, and previous experience with the test substance in repeat dose toxicity studies.
What are pros and cons of flow cytometric vs microscopic analysis?
Microscopic analysis utilizes a fluorescent nucleic acid dye to distinguish immature erythrocytes from mature erythrocytes (also known as reticulocytes) by color and to identify brightly stained micronuclei in these cells, typically, 4,000 polychromatic (immature) erythrocytes are scored per animal. Generally, microscopy is used for assessing micronuclei formation directly in bone marrow and this assay format has been in use for many decades.
Flow cytometry utilizes antibodies to differentially label surface proteins to distinguish populations of immature erythrocytes from mature erythrocytes and platelets in peripheral blood; a DNA stain is used to gate out nucleated cells (leukocytes) and to identify micronuclei in erythrocytes. Typically, 20,000 polychromatic erythrocytes are scored per animal. Flow cytometric analysis provides a more rapid and robust means to enumerate micronucleated cells without potential for scorer bias. Evaluation of micronucleated erythrocytes in blood serves as a surrogate measurement for induction of micronuclei in bone marrow and permits multiple time points to be assessed using the same animals. Both analysis formats are accepted by regulatory agencies.
Do I need to collect plasma for bioanalysis?
Proof of bone marrow exposure is required to support a negative result in the micronucleus assay. In the absence of clinical signs indicative of systemic exposure, a statistical change in the immature to mature erythrocyte ratio, or preexisting data demonstrating bone marrow bioavailability using the same species and administration route, direct detection of test material in the bone marrow or plasma is necessary. No demonstration of bone marrow exposure is required when the test material is administered intravenously.
Which dose routes are available?
Test material is most frequently administered by oral gavage, but intravenous, subcutaneous, intramuscular, and nasal instillation administration routes can be used. Intraperitoneal injection is not recommended without good justification. Administration via diet and drinking water are typically reserved for longer dosing regimens.
Explore other genetic toxicology assays:
| Mutation | Cytogenetic Damage | DNA Damage |
|---|---|---|
| Ames assay | In Vitro Micronucleus assay | Comet assay |
| HPRT assay | Chromosome Aberration assay | |
| Mouse Lymphoma assay | In Vivo Micronucleus assay | |
| Pig-a assay |


